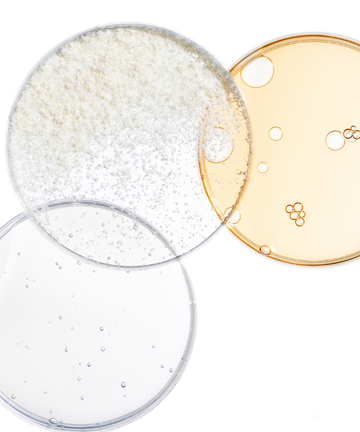

Moisture-Locking
FACE STICK
A take-anywhere-apply-anytime ally for healthy skin. Lightweight and nourishing, this compact face balm glides effortlessly across skin to lock in essential moisture while helping protect against damage from daily environmental stressors, like pollution.
Size: 10g
With potent ingredients like biotech-derived Naringenin and skin-identical lipids like ceramides and squalane, the face stick is clinically proven to boost moisture instantly and over time and reduce redness for smoother, more comforted skin.
The moisture-locking face stick is safe for all skin types, including sensitive skin.
01 Glide over skin 02 Gently massage in as needed Can be used on freshly cleansed skin, as a final step of your skincare routine, or even dabbed on over makeup, to boost your glow and prevent moisture loss at home or on-the-go.



WEEK 0 | WEEK 8
Clinically proven to boost moisture instantly and overtime while simultaneously reducing visible redness
94% have soothed skin
91% say skin looks and feels more moisturized, with moisture locked in
88% say skin feels boosted and comforted
View the full list of ingredients